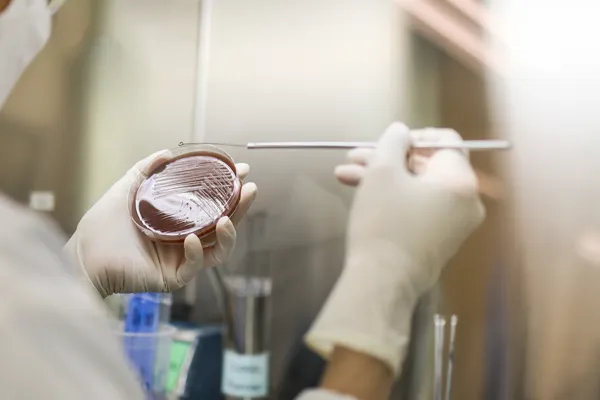
A doctor carrying out a gonorrhoea test

Dr Tan Kok Kuan
Men’s Health & Sexual Health Doctor
MBBS (S’pore), Cert. Men’s Health, Cert. Clinical Dermatology,Member, Academy for Men’s Health (Singapore)Member, Singapore Association for the Study of ObesityMember, International Society of Sexual Medicine

Gonorrhoea is one of the most common bacterial sexually transmitted infections (STIs) affecting men worldwide. Although it is highly treatable, many infections go unnoticed because symptoms may be mild or absent in the early stages. As a result, some men may unknowingly transmit the infection to sexual partners.
If left untreated, gonorrhoea can lead to complications and increase the risk of transmitting or acquiring other sexually transmitted infections. Early diagnosis through testing and prompt treatment are important steps in protecting both personal health and the health of sexual partners, and can help prevent complications.
Gonorrhoea is a common STI caused by the bacterium Neisseria gonorrhoeae. It is primarily transmitted through unprotected vaginal, anal, or oral sex with an infected partner. The infection can affect several parts of the body, including the urethra, rectum, throat and eyes.
In men, gonorrhoea most commonly infects the urethra and penis. Some men may develop noticeable symptoms, while others may have mild or no symptoms at all. Because the infection can sometimes remain unnoticed, individuals may unknowingly pass it to sexual partners.
Gonorrhoea symptoms in men usually appear within a few days to two weeks after exposure, although some individuals may not experience any noticeable symptoms. When symptoms do occur, they most commonly affect the genitals.
Possible symptoms of gonorrhoea in men include:
Gonorrhoea can also infect other areas of the body, depending on the type of sexual contact that spread it. For example, throat infections may occur after oral sex, and rectal infections may develop after anal sex.
Gonorrhoea can often be prevented with the right precautions and awareness of sexual health risks. Taking proactive steps to reduce exposure and seeking regular medical screening can help lower the likelihood of infection and support overall sexual well-being.
Practicing safe sex can help lower the spread of sexually transmitted infections and diseases. Using condoms consistently and correctly during vaginal, anal and oral sex can reduce the risk of gonorrhoea transmission by preventing direct contact with infected bodily fluids and mucous membranes.
Routine sexually transmitted infection (STI) screening helps detect infections early, even when no symptoms are present. Regular testing is particularly important for individuals who have multiple partners or new sexual partners.
Reducing the number of sexual partners you engage with can lower the risk of exposure to gonorrhoea and other STIs. Maintaining mutually monogamous relationships where both partners have tested negative can further reduce risk of transmission.
Open discussions about sexual health, STI testing and recent exposures can help partners make informed decisions. Testing before starting a new sexual relationship may also help reduce the likelihood of transmission.
If you notice symptoms such as unusual discharge, pain during urination, or genital irritation, it is advisable to avoid sexual activity and seek medical evaluation. Early diagnosis and treatment help prevent spreading the infection to others.
As gonorrhoea is a bacterial infection, it is typically treated with antibiotics. In many cases, doctors may recommend testing and treatment for other sexually transmitted infections such as chlamydia, which can occur alongside gonorrhoea.
It is important to complete the full course of medication exactly as prescribed, even if symptoms improve quickly. Patients are usually advised to avoid sexual activity until treatment is completed and a doctor confirms that the infection has cleared.
Sexual partners should also be informed and tested where appropriate to reduce the risk of reinfection and further transmission. Follow-up testing may sometimes be recommended to ensure the infection has been successfully treated.
If gonorrhoea is not treated promptly, the infection may lead to complications that affect long-term health. In men, untreated gonorrhoea can spread to other parts of the reproductive system and cause inflammation or pain in the testicles, a condition known as epididymitis. In some cases, this may affect fertility.
The infection can also spread to the bloodstream in rare situations, leading to a condition known as disseminated gonococcal infection (DGI). This may cause symptoms such as joint pain, skin lesions, or fever and requires urgent medical attention.
In addition, untreated gonorrhoea can increase the risk of acquiring or transmitting other sexually transmitted infections, including HIV.
Men should consider getting tested for gonorrhoea if they suspect that they have contracted it through any means. Some of the most common reasons for pursuing a test are:
Understanding the symptoms, treatment methods and long-term consequences of gonorrhoea can help patients recognise the need for timely medical care and take appropriate steps to protect their own health and that of their sexual partners.
If you are experiencing symptoms, believe you may have been exposed to gonorrhoea, or would like routine sexual health screening for peace of mind, it is advisable to seek medical advice early.
At Dr Tan Medical Center, we provide confidential STI screening and comprehensive sexual health care in a discreet clinical setting. Dr Tan Kok Kuan has extensive experience in men’s sexual health and offers personalised advice, testing and treatment plans tailored to each patient’s needs.
Contact us today to arrange a confidential consultation and STI screening.

Dr Tan Kok Kuan
MBBS (S’pore), Cert. Men’s Health, Cert. Clinical Dermatology, Member, Academy for Men’s Health (Singapore) Member, Singapore Association for the Study of Obesity Member, International Society of Sexual Medicine
Dr Tan Kok Kuan is an experienced doctor specialising in men's health, sexual health and medical weight loss. With over 20 years of clinical experience, he offers confidential and effective screening and treatment services. Notably, Dr Tan was one of the key authors of Singapore’s National HIV PrEP Guidelines and the national blueprint to end HIV transmission by 2030. Dr Tan frequently speaks at local and international conferences and has been featured in the media, where he helps raise public awareness around men’s health and sexual health.
“Every patient deserves our fullest attention.”
10 Sinaran Drive #09-30, Novena Medical Centre, Singapore 307506
Tel: (+65) 6513 0359 | WhatsApp: (+65) 9750 5037
Operating Hours:
Monday to Friday: 8:30 AM to 6:30 PM
Saturday: 9:00 AM to 2:00 PM
Closed on Sundays and Public Holidays